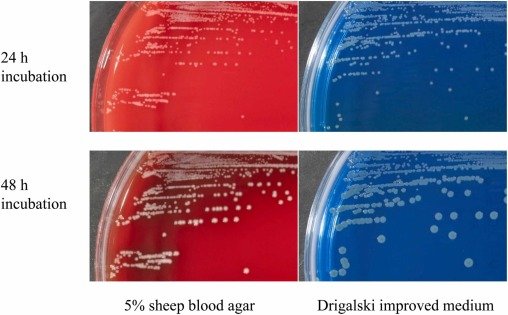

Japan Reports First Bloodstream Infection from C. metallidurans
In a study that was published this week, scientists from Japan reported the first case of a bloodstream infection caused by the bacterium Cupriavidus metallidurans.
The authors of the study “First Case of Bloodstream Infection Caused by Cupriavidus metallidurans in Japan” are Kizuki Hosoya, Haruka Yokoo, Satomi Takei, Naoya Ogura, Ayako Nakamura, Hidenori Yoshii, Tomomi Matsubara, and Tadashi Miyazaki.
As explained, the patient was a 77-year-old man hospitalized for treatment of heart failure and diabetes. To date, only five cases of bloodstream infection caused by C. metallidurans have been recorded, all in Canada and Italy.
Precise identification is difficult
In the report, the scientists explained when the bacterium was first discovered, as well as the challenges associated with its detection. This bacterium was first identified in 2001 as a new species within the genus Ralstonia, which was previously classified under the genus Pseudomonas. Three years later, in 2004, it was reclassified into the genus Cupriavidus, a group of gram-negative bacteria that do not ferment glucose. Unlike related genera such as Burkholderia and Ralstonia, C. metallidurans does not hydrolyze sugars, and its numerous unstable properties make precise identification difficult. Although mass spectrometry can provide results comparable to genomic analysis, databases contain very little information on this bacterium, further complicating detection. Therefore, final identification is usually confirmed through analysis of the 16S rRNA gene.
About the patient
The patient had been treated as an outpatient for three years for heart failure, with regular glycemic monitoring in the cardiology and endocrinology departments of their hospital. On the 83rd day of hospitalization, the patient developed a fever of 38.0 °C. This day was designated as Day 1 to mark the onset of a new clinical event. On the following day, a blood culture was positive for gram-negative bacilli, and antibiotic therapy with cefmetazole (2 g twice daily) was initiated. On the fourth day, after antibiotic susceptibility testing, therapy was changed to cefepime (1 g). Due to liver dysfunction, therapy was switched to levofloxacin (250 mg daily) on the tenth day. Antibiotic therapy was discontinued on Day 17, following improvement in the patient’s condition.
Further cases may emerge, particularly among elderly or immunocompromised individuals
C. metallidurans is a heavy metal–resistant bacterium commonly found in contaminated environments, including industrial sites, and has been detected in Japanese soil. To date, only five human infections have been reported, and all have been bloodstream infections in patients with central venous catheters. The exact route of infection is unclear, but environmental sources, such as water, may have played a role. Most bloodstream infections caused by Cupriavidus species respond well to treatment. The patient improved with cefepime and levofloxacin, guided by antimicrobial susceptibility testing.
“Given that C. metallidurans is present in Japan’s environment and nosocomial transmission has been reported abroad, further cases may emerge, particularly among elderly or immunocompromised individuals,” the scientists concluded.
Image: Gram-stained blood culture showing Cupriavidus metallidurans from Hosoya et al. (First Case of Bloodstream Infection Caused by Cupriavidus metallidurans in Japan).

